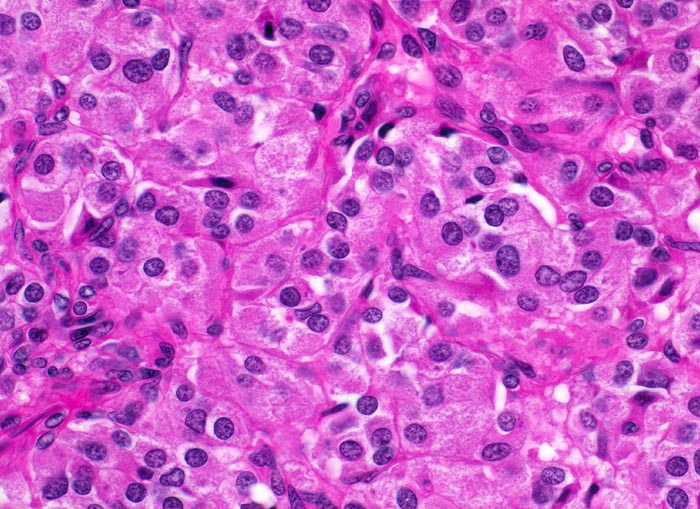

PathoPic – image database / PathoPic ID 4853 - medulläres Schilddrüsenkarzinom
de
Diagnose
medulläres Schilddrüsenkarzinom
Diagnose Gruppe
maligner Tumor
Topographie
Schilddrüse
Topographie Gruppe
Endokrinium
Beschreibung
Die polygonalen Tumorzellen bilden Zellballen, welche von schmalen Bindegewebssepten umsponnen werden. Die Tumorzellen haben reichlich feingranuläres Zytoplasma und runde Kerne mit feinkörnigem Chromatin.
Zusatzbefund
Mehrere scharf begrenzte weisse Knoten in beiden Schilddrüsenlappen von bis zu 8mm Durchmesser.
Klinik
Beim Vater der Patientin wurde ein bilaterales Phäochromozytom diagnostiziert und in der Folge eine multiple endokrine Neoplasie vom Typ 2A. Im Familienscreening wurde bei der Patientin eine Mutation im Ret-Protoonkogen nachgewiesen und eine prophylaktische Thyreoidektomie durchgeführt.
Bilder Typ
Histologie
Vergrösserung
400
Alter
21
Geschlecht
unbekannt
Datum
Ersteintrag: 11.06.2002